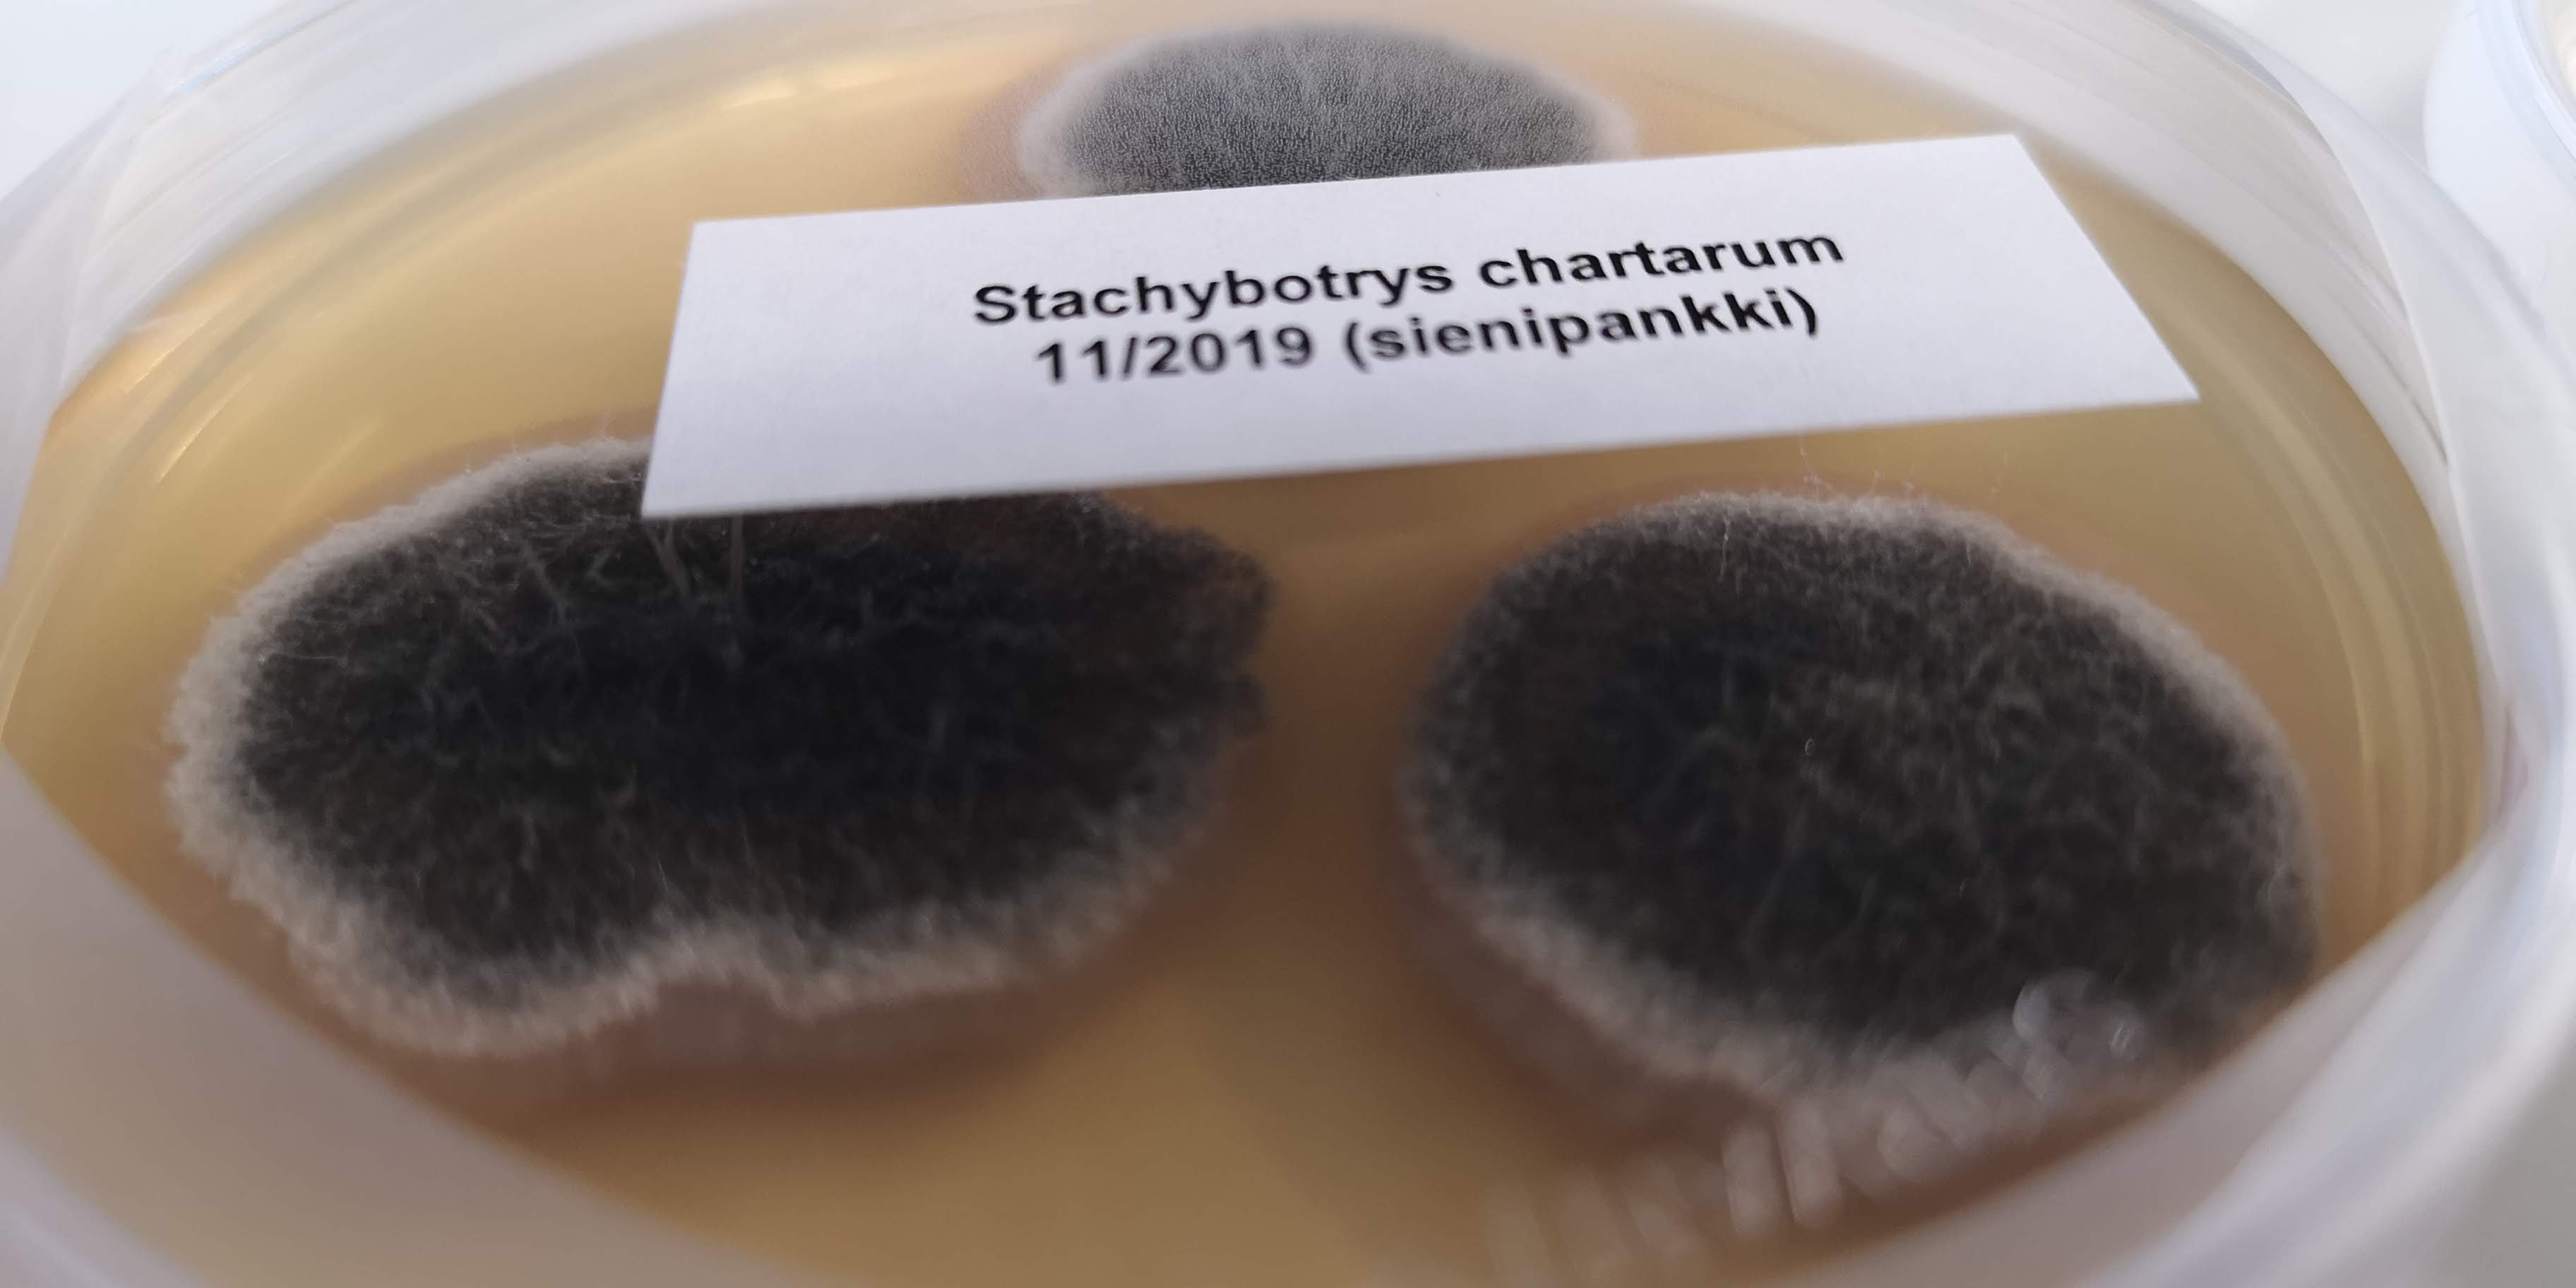

Homesienten pahis Stachybotrus chartarum
Yhteystiedot ja Toimialue
Ensisijainen toimialueemme on Pirkanmaa ja sen lähialueet. Hirrenveistopaikat ovat Tampereella ja Sastamalassa. Tarvittaessa veistäjämme tekevät hirrenveistoa asiakkaan rakennuspaikalla.
Tilaukset ja tiedustelut:
Tj. Jan-Erik Tarpila
jan-erik@tarpila.com
040 514 2335Haluatko vanhan näköistä
Jokainen savusauna, aitta, laavu tai muu hirsirakennus on ainutlaatuinen. Käyttämiemme vanhojen hirsien erityispiirteet sanelevat jokaisen hirsirakennuksen rakentamisen. Rakennuksen historiallinen henki korostuu rakennuksessa käytettyjen vanhojen leveiden lankkujen, ikkunapielien ja ovien luomasta nostalgisesta tunnelmasta.

Jätä kommentti